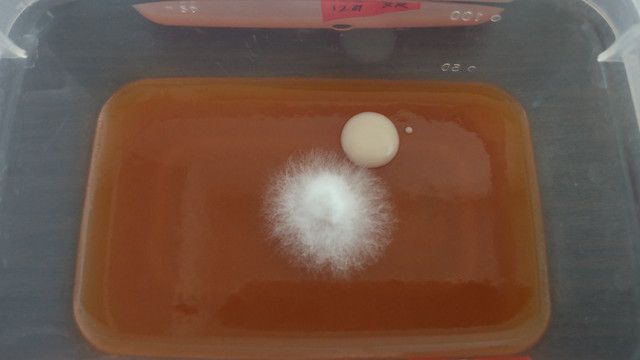
培地、菌糸、雑菌

もれ郎は普段の作業でどういったことに気を付けているのか、考えてみました。
どうも、元きのこ研究者のもれ郎です。
もれ郎はこれまでに、当ブログの読者さんからTwitter等で「家できのこ栽培」に関する質問のDMをいただいたことが何回かあります。多くは「ブログの真似してるけどうまくいかない、アドバイスが欲しい」というコメントでした。
そのコメントの内容は詳しくは書きませんが、もれ郎にいくつかの重大な気づきを与えてくれました。すべての論点、問題点が無菌操作に集約されていたのです。
「やっぱ家庭きのこ栽培に無菌操作を求めるのは無理だったのでは……」と思う一方で、さぼり症のもれ郎は無菌操作不要の栽培方法を未だに開拓できていません。
そして、DMをもらって振り返ってみて思いましたが、もれ郎は無菌操作の方法を的確にお伝えできているのかというと、実はそんなこともありませんでした(すみません……)。今までお伝えしていた方法は、肝心なところが抜けていたり、クセがある方法だったのです。
例えばもれ郎は文無しのケチですので、テクニックでカバーできる部分けど本当はやったほうがいいことは省略しています。そのため、経験のない方にとってやったほうがいいことたあったほうが良いものは、あんまり紹介できていなかったです。
そして、皆さんも既にお気づきかと思いますが、もれ郎には変なこだわりがあります。これが現実のもれ郎をも苛むのですが、それはこのブログでも悪さをしてしまい、やはり未経験の方には優しくないやり方を採用していたりしました。
そこで今回は、無菌操作で苦しんでる方々……例えば、きのこの分離操作を解説!自分で種菌を作れるようになる方法【組織分離】 - さかなきのこあたりの記事をご覧になってチャレンジしてるけどうまくいかないを対象に、ある程度モノは必要になるけど、難易度を格段に下げるポイントをお伝えしてみたいと思います。
「きのこから菌糸の分離がどうやっても無理」
「もれ郎の言う通りにやってるのにカビしか生えてこないじゃないですかー!!」
「たまに上手くできるけど半分くらいは失敗するんだよね」
そんな方の助けになれば幸いです。
大前提:無菌操作の成否は「確率」
初めに、重要なことをお伝えしておきます。家庭で行う無菌操作に絶対はありません。
なぜならば、家庭の部屋などの空間は無菌とは程遠いからです。
極端な話、培地等に埃やカビが全く混入しなければ、雑菌汚染(コンタミ)は起こりません。しかし、家庭にはクリーンルームやクリーンベンチなどの特殊設備はありませんので、埃やカビが存在しない空間を作り出すことは不可能です。そうなってくると、重要なのがどれだけコンタミリスクを下げることができるか、ということになります。
つまり、作業スペースに漂う埃やカビをどれだけ減らせているか、埃が混入しづらい作業環境ができているか、操作中に埃やカビの混入を招きやすいやり方をしていないか、極論を言うとこの三点です。
これからお伝えするコツは、以上のいずれかに該当するものになります。
無菌操作での失敗しにくくなるためのポイント
「これは別に書かなくてもいいかなー」と思うものも含め、リストアップしてみました。時系列で書いているので、初めから終わりまでをイメージしてみてください。
1.部屋をきれいにする
普通のご家庭にはクリーンルームなどないと思います。おそらくあなたは私同様、どこかの部屋の隅でこそこそと無菌操作をすることを企画していると思います。
まずはその部屋をきれいにしましょう。
「きれい」といっても、脱ぎ散らかした服がその辺にあるくらいだったらまあいいです。
問題は、埃がたまっていたり、カビの生えた食べカスが放置されていたりとかです。
こういう部屋は、コンタミのもと(汚染源)となる埃やカビなども多く漂っています。まずは漂う埃を減らす工夫をしてみるのです。
とはいうものの、実はこれ、そんなに効果は高くないです。後に触れますが、作業スペースを超きれいにしたり、手をきれいにするほうがはるかに重要です。
しかし、部屋をきれいにすることには副次的な効果もあるので軽視はできません。つまり、このような状態の部屋はかなり荒んだ部屋であり、あなたやご家族の精神衛生上よろしくないと言えます。掃除をすることで、無菌操作の成功率向上だけではなく、精神衛生の向上や家庭円満につながるでしょう。やらない手はないです。
あと、きれいさとは関係ないですが、ペットのいる部屋は作業部屋としては避けたほうがいいかもしれません。理由は同じです。
2.培地や器具を滅菌し、超きれいな場所(後述)に置いておく
部屋を作業したあなたは、さっそく無菌操作をするための準備に取り掛かります。
そう、培地や器具の滅菌です。
培地はもちろん、後で触れる火あぶり(火炎滅菌)ができない器具についても滅菌しておきましょう。
滅菌の方法は簡単です。圧力鍋に入れて、圧がかかってから20分くらい加熱すればOKです。器具はお湯に沈めて茹でるのではなく、蒸します。
普通の鍋でゆでたり蒸したりするだけではだめですよ。温度が足りなくて雑菌を処理しきれないためです。
加熱が終わったら、超きれいなところで冷まします。おすすめは、完全に冷めるまで圧力鍋で放置し、作業直前に作業スペースに移すことです。
なぜならば、加熱後の圧力鍋の中のほうが鍋の外より圧倒的にきれい(雑菌つきの埃が少ない)からです。加圧が終わってしまえば外の空気もある程度入ってきますが、それでも部屋の中よりマシだと思います。
滅菌した器具等が埃や雑菌だらけの空気にさらされる時間が長いほど、後の作業でのコンタミ確率が高まってしまいます。これはどれだけ部屋をきれいにしていても防げません。
しかし、圧力鍋の中は加熱により、冷めた後も超きれいな状態を比較的長く維持できます。その中に入れて作業直前まで寝かせておけば、汚染源にさらされる時間が極限まで短くできるという作戦です。
どうせ滅菌したての培地はアチアチなので、すぐに接種などできません。滅菌した翌日に接種するスケジュールを立てておきましょう。もれ郎も普段はそうしています。
3.作業スペースを超きれいにする

実際に無菌操作を行う場所を確保します。段ボールやプラダンで空気が流れない一角を作り作業スペースにするのがおすすめです。なくてもできますが、難易度は上がります。もれ郎は200円で作業スペースを自作しました。
【自作】きのこ栽培の接種用ブースを200円程度でつくってみた。 - さかなきのこ
そして、作業スペースを徹底的にきれいにします。埃を取るとかそういうレベルではなく、除菌もします。具体的には、アルコールスプレーを机や作業スペースの側面、天面に吹き付けて拭いたりします。研究室だと、紫外線が出るランプを点けて殺菌したりもします。
ご家庭でやるとすると、次亜塩素酸水を吹き付けて拭きとるという方法が無難です。アルコールスプレーでもいいですが、火をつけたときに気化したアルコールに引火するおそれもあるので少々危険です。もれ郎は慣れているので激安アルコールゲルでその辺を拭いていますが、おすすめはしません。
また、作業スペースには物を置きすぎないようにします。むしろ、作業スペースには必要なものしか置いてはいけません。
必要なものとは、これから接種をする培地や種菌の他、後述する火元(アルコールランプ等)、火炎滅菌した器具を冷ます用のアルコール、そして器具類です。
そして、いくら必要だからといっても、埃まみれの種菌容器など汚いものを持ち込んではダメです。超きれいにした意味がなくなりますからね。汚いものを持ち込む場合は、外側をアルコール等で拭いておきましょう。
4.部屋の空気の流れを止める
窓を閉めたりサーキュレーターや扇風機を止めるなど、部屋の空気が動かないようにします。部屋にある汚染源が吹き飛んでくるのを防ぐためです。
5.作業直前に手を洗う
あなたはようやく作業に取り掛かろうとします。が、その前に手を洗います。石鹸で洗い、手を拭いた後にはアルコールで殺菌するのが望ましいです。
そして、手を洗ったら余計なところは一切触ってはいけません。顔を掻いたり、超きれいにしていてない部屋のどこかを触ったりすると、手が汚染されるからです。また、洗ったとはいえやはり手は汚いので、培地や容器の口を触ってもいけません。きのこの組織分離のときも、むき出しにした内側はさわってはいけませんし、触った部分からきのこ片をつまみ出すのは失敗の元です。
6.作業中はしゃべったり息を吹きかけたりしない
さて、作業スペースにつきました。ここから先、あなたは自分の吐く息や唾にも気を付ける必要があります。
マスクをつけるのが無難です。そして、しゃべったり歌ったり、翌日の仕事のことを思い出してため息をついたりしないようにします。くしゃみをするときは顔を横に向けましょう。
7.火の近くで作業をする

アルコールランプやガスボンベなどを作業スペースに入れ、火をつけてそのすぐそばで作業をします。
火の熱によって上昇気流が起きるので、そのすぐ近くでは埃などが自然落下してきづらくなる、という理屈です。
これ、実験室とか設備がそろった場所で行う本物の無菌操作だと不要だったりしますが、ご家庭だとけっこう重要です。理由はもう分かりますね。ご家庭の部屋の埃の量は、実験室と比べて桁違いに多いからです。
そうでなくても、後に触れる火あぶり作業の都合上、火はマストです。
8.無菌部分の露出は極力短時間かつ最小限にして細心の注意を払う
種菌を培地に入れる時や組織分離できのこを裂いてきのこ片を取り出すとき等、無菌部分を露出させるシチュエーションは多々あります。このときの時間を最小限することがポイントです。
露出している時間が長ければ長いだけ、埃がついてしまう確率が上がりますからね。
そして、容器のフタはガバッと大きく開けすぎないようにします。作業がやりづらくならない程度に、最小限開きます。
また、容器を長く開ける場合、なるべく容器の口が真上を向かないように注意します。例えば、種菌の容器を開ける際は少し傾けておきます、可能であれば下向きにしてもいいです。
そして、これも重要かつ見落としがちですが、作業中に物をとったりするときに手や物が露出している無菌部分の上を通らないようにしましょう。
9.菌糸やきのこ、汚い部分を触った器具は火あぶりする(そしてよく冷ます)
種菌をかき出した後のスプーン、きのこ片を切り出した後のメスやピンセット、机や容器の外側に触れてしまった器具は、次に無菌部分に触れる前にかならず火あぶりします。
これらの器具に雑菌がついてしまっていた場合、その後の作業で触れるすべてのものが雑菌で汚染されてしまう(コンタミしてしまう、と言います)ためです。
そして、火あぶり後に次のものを触る前に、冷やしておきましょう。きのこや菌糸にアチアチのスプーン等を押し付けると死んでしまいます。
手順としてはこんなかんじです。
まず、器具に培地などがついていてひどく汚れている場合は、火あぶりする前にアルコールでゆすいで汚れを落とします。この時に使うアルコールは燃えやすい無水エタノールがおすすめです。
次に、器具を火であぶります。あとで冷ますので、わりとじっくりでいいです。
そして、アチアチになった器具を冷ますべく、アルコールの中に入れます。この時、ジューっと音がしますが大丈夫です。ただ、火がついたもの(培地が付いたまま燃やしてくすぶっているスプーンとか)は絶対に近づけたりしないでください。火事のもとです。
最後に、器具についたアルコールを飛ばす意味で、一瞬だけ器具を火にくぐらせます。
これでOKです。
10.ガラス容器の口も火あぶりする
あなたがガラス容器を使っている場合、ガラス容器の口も火あぶりすることをお勧めします。容器の口の周りは手で触れやすいので、あまりきれいではないからです。
ちなみに、もれ郎はガラス製ではないプラスチック容器も一瞬だけ火あぶりしたりします。埃を焼き飛ばすようなイメージです。
重要度が高いものはどれか
思いついたものを書けるだけ書いてみましたが、もれ郎は全部に細心の注意を払っているわけではないです。
例えば、もれ郎の作業部屋はかなり埃がたまっていますし、作業スペースに持ち込むものもそんなにきれいにしていません。
では、なんであまり失敗しないかというと、もちろん慣れもありますが、たぶん大部分を占めるのは次の2点なのではないかと思います。
菌糸やきのこ、汚い部分を触った器具は火あぶりする(そしてよく冷ます)
無菌部分の露出については慣れてしまえば簡単です。もれ郎には癖として染みついているのですが、みなさんはこれから習得していく必要があります。もれ郎がまれにアップする動画を見たり、実際にやってみたりして少しずつ習得していくしかないです。
そして火あぶりについてですが、もれ郎はこまめになんでも火あぶりします。キンデル等のプラスチック製容器も一瞬だけ火あぶりにしますし、ピンセットとかは基本的に毎回火あぶりします。埃が無菌部分に入ってしまってはおしまいですが、そうなる前に燃やしてしまえば何とかなると思っているためです。
終わりに:慣れれば簡単
以上、無菌操作のコツを書いてみました。
いろいろ書きましたが、一度コツをつかんでしまえば大したことはないです。
ちょっと普段は気にすることがないポイントがいくつかある程度です。ベテランさんにしかできないなんてことはありません。
これさえできれば、家庭きのこ栽培はほぼなんでもできるに等しいです。
シイタケを一から栽培したりエコな栽培方法を編み出してみたり、いろいろと試してみようじゃありませんか。
最後にやや脱線します。本記事の書き出しではDMをいただいたことにしれっと触れましたが、これはもれ郎の人生において結構な衝撃でした。ブログ始める前は、まさか私にそんなことが起ころうなどとは考えもしませんでしたので。
このブログを誰かが見てくれているだけではなく、書いてある内容を実際に試そうとしてくれている。しかも、うまくいかなくても「この嘘吐き糞ブログめが」などと唾棄せず内容を信じてくれて、さらにはもれ郎が伝えきれていないことを直接聞き出そうとしてくれている熱心な方までいるのです。
こんなにうれしいことはありません。今後も当ブログで分かりづらいことやうまくいかないことがあれば、ぜひコメントをください。もれ郎も勉強するきっかけになりまし、記事ネタにもなりますのでwin-winなのです。
近いうちに、道具篇もまとめます。
もれ郎